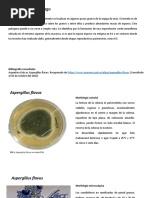

0% encontró este documento útil (0 votos)
922 vistas3 páginasAbsidia Corymbifera
Absidia corymbifera es un hongo filamentoso que crece rápidamente entre 35-52°C y presenta estructuras reproductivas llamadas esporangióforos de forma verticilada. Causa infecciones oportunistas en humanos que pueden afectar el cerebro, pulmones, tracto gastrointestinal o diseminarse por el cuerpo. Aspergillus flavus es un hongo que puede causar enfermedades alérgicas o invasoras en pulmones u otros órganos en humanos inmunocomprometidos. Forma colonias amarillo
Cargado por
Mikel AngelottyDerechos de autor
© © All Rights Reserved
Nos tomamos en serio los derechos de los contenidos. Si sospechas que se trata de tu contenido, reclámalo aquí.
Formatos disponibles
Descarga como DOCX, PDF, TXT o lee en línea desde Scribd
0% encontró este documento útil (0 votos)
922 vistas3 páginasAbsidia Corymbifera
Absidia corymbifera es un hongo filamentoso que crece rápidamente entre 35-52°C y presenta estructuras reproductivas llamadas esporangióforos de forma verticilada. Causa infecciones oportunistas en humanos que pueden afectar el cerebro, pulmones, tracto gastrointestinal o diseminarse por el cuerpo. Aspergillus flavus es un hongo que puede causar enfermedades alérgicas o invasoras en pulmones u otros órganos en humanos inmunocomprometidos. Forma colonias amarillo
Cargado por
Mikel AngelottyDerechos de autor
© © All Rights Reserved
Nos tomamos en serio los derechos de los contenidos. Si sospechas que se trata de tu contenido, reclámalo aquí.
Formatos disponibles
Descarga como DOCX, PDF, TXT o lee en línea desde Scribd